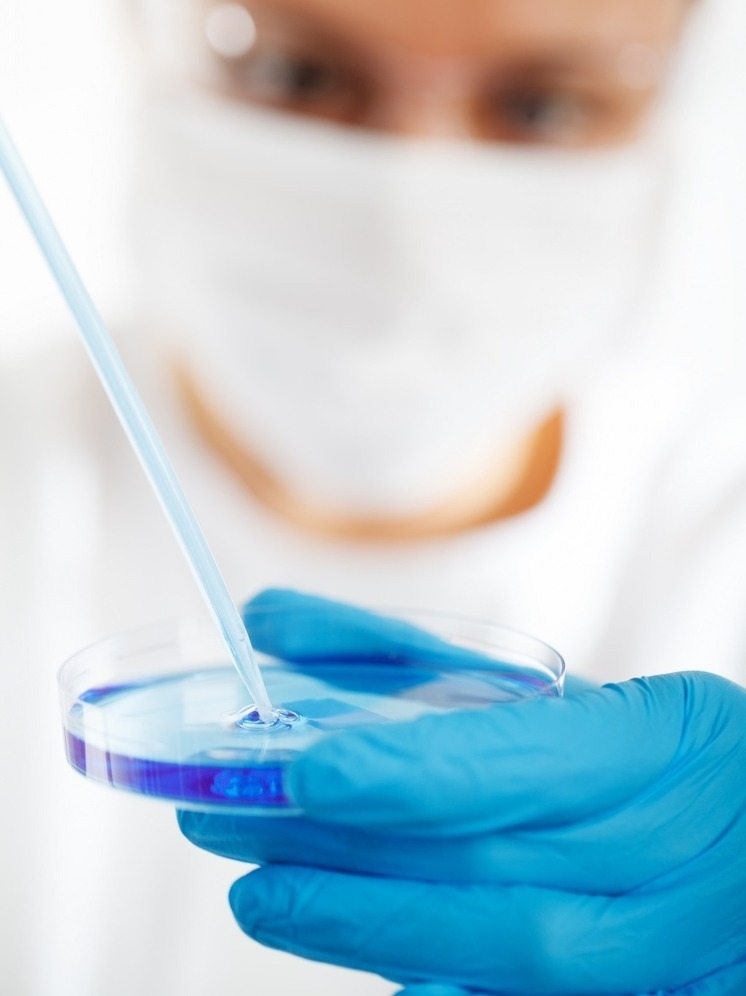
Убыточность нижегородских научных организаций выросла в 12,5 раз

Нижегородстат подготовил новый статистический документ, который показывает, что научные организации региона за период с января по август текущего года столкнулись с резким увеличением убытков, которые возросли в 12,4 раза по сравнению с аналогичным периодом предыдущего года.
Общая сумма убытков достигла 89 миллиардов рублей, в то время как прибыль составила лишь 2,8 миллиарда рублей, что демонстрирует снижение на 91,6% по сравнению с прошлым годом.
Несмотря на значительный рост убытков, соотношение прибыльных и убыточных организаций практически не изменилось: 61,4% организаций по-прежнему демонстрируют прибыльность, а доля убыточных составляет 38,6%.